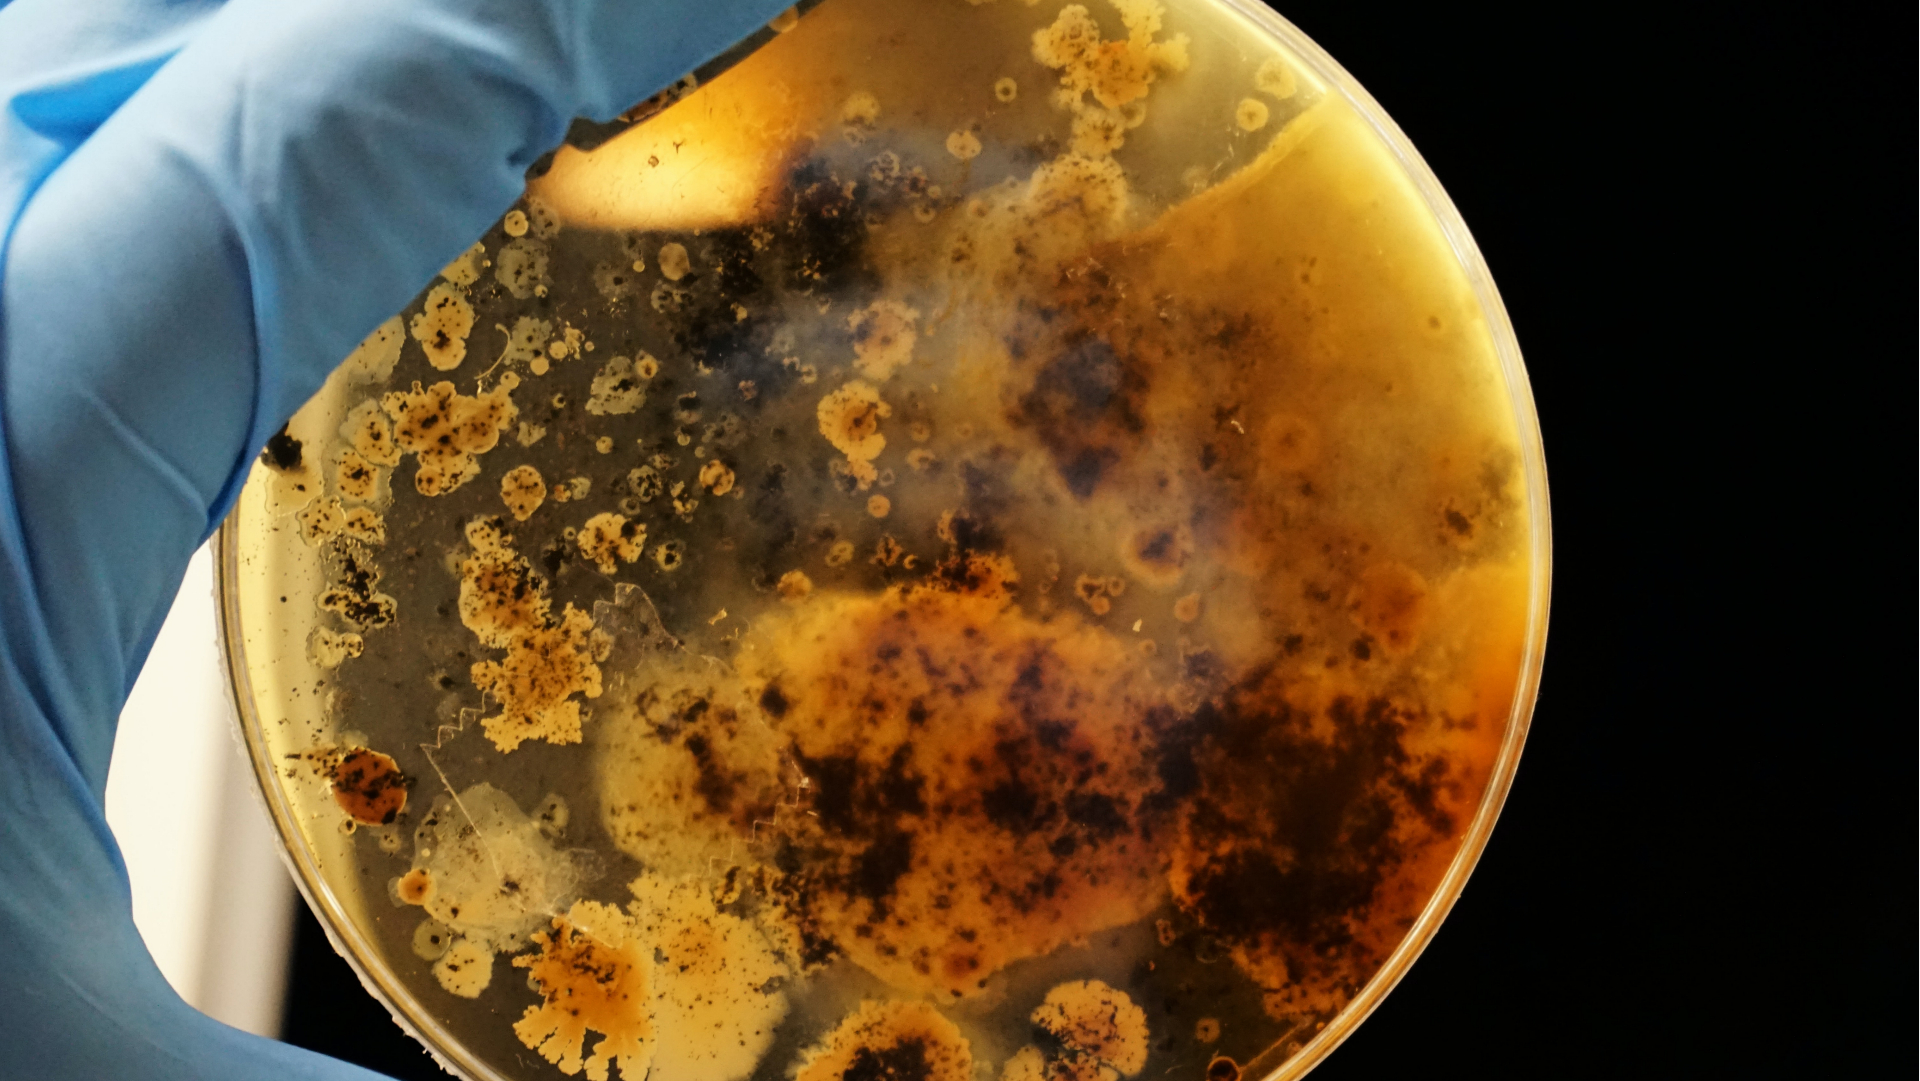
petriho miska s baktériami

Prelomový objav: Vedcom sa podarilo naučiť umelý mozog hrať jednu z najstarších počítačových hier
- Vedcom z Austrálie sa podarilo naučiť „mozog v miske“ hrať Pong
- Ide o prvý experiment svojho druhu
- Objav môže pomôcť vo vývoji nových technológií
- Vedcom z Austrálie sa podarilo naučiť „mozog v miske“ hrať Pong
- Ide o prvý experiment svojho druhu
- Objav môže pomôcť vo vývoji nových technológií
Veda neustále napreduje míľovými krokmi. Vedci v skúmavkách pestujú myši, ktoré nepotrebujú žiadnych rodičov, či vytvárajú mužskú antikoncepciu pomocou obyčajnej žihľavy. Avšak niektoré nové štúdie sú ešte fascinujúcejšie. Jedna z nich pochádza z Austrálie.
Jednoduchá hra, zložitý experiment
Poznáš Pong? Ide o jednu z najstarších počítačových hier. Jej konceptom je odrážať „loptičku“ medzi dvoma hráčmi pomocou malých „plošín“. Ak sa to jednému z hráčov nepodarí a inkasuje akýsi „gól“ tým, že „loptička“ sa dostane za hranicu jeho „plošiny“, jeho oponent získa bod. Jednoduché.
Čo však nie je jednoduché, je naučiť zhluk neurónov v miske porozumieť konceptu tejto hry a dokonca ich naučiť ju efektívne hrať. Ako však informuje web France24, presne to sa podarilo tímu vedcov z Austrálie. Môže ísť pritom o skutočne prelomový objav.
Autorom štúdie je Brett Kagan, odborník na neurológiu a vedúci vedecký pracovník kortikálnych laboratórií v Melbourne, so svojím tímom. Cieľom štúdie bolo zistiť, či je možné využiť inteligenčný potenciál neurónov, ktoré sú súčasťou takmer všetkých živých organizmov.
Tím vedcov do „misky“ uložil približne 800 000 neurónov (čo predstavuje približne rovnaký objem neurónov ako v mozgu čmeliaka), ktoré pochádzali z kmeňových buniek ako myší, tak aj ľudí, informuje ScienceAlert. Pomocou vysielania pravidelných elektrických signálov do buniek v nádobe boli vedci schopní naučiť neuróny hrať Pong efektívne a správne.
Fascinujúce výsledky
Ide o vôbec prvý experiment dokazujúci, že neuróny majú schopnosť sa prispôsobiť vykonávaniu konkrétnej úlohy a dokonca sa zlepšovať v prípade „dobrej odozvy“. Odozvou boli práve pravidelné elektrické signály, ktoré neurónom „dodávali pocit“ poriadku a kontroly nad svojím okolím, čo je pre tieto mozgové bunky priaznivým stavom.
Naopak, v prípade zlyhania v splnení úlohy, a teda v prípade prehry v Pongu, vedci neuróny „potrestali“ vysielaním nepravidelných signálov, píše sa v štúdii zverejnenej v magazíne Neuron. Mozog v miske hrajúci Pong si môžeš pozrieť vo videu priloženom nižšie.
Nové zistenia austrálskych vedcov majú potencionálne využitie v počítačových technológiách a je dokonca možné, že by mohli byť mnohokrát výkonnejšie než naša súčasná umelá inteligencia. Ako ďalej vysvetľuje ScienceAlert, najväčšou nevýhodou súčasných počítačových systémov je ich schopnosť učiť sa vykonávať nové úlohy.
Ak chceme totižto počítač niečo naučiť, je potrebné mu najprv dodať obrovské množstvá dát, skrz ktoré sa následne princípom „pokus-omyl“ dokáže učiť vykonávať úlohy. Oveľa efektívnejšie sú však živočíšne neuróny. Kagan pre priblíženie používa príklad psa, ktorý sa „nové triky dokáže naučiť pokojne aj na druhý či tretíkrát“.
„Nikdy predtým sme neboli schopní pozorovať správanie týchto buniek vo virtuálnom prostredí,“ cituje ďalej vedúceho výskumu portál Futurism.
„Dokázali sme vytvoriť uzavreté prostredie, ktoré dokáže reagovať na to, čo sa v bunkách deje, stimulovať ich pomocou relevantných informácií a následne ich pozmeniť ich takým spôsobom, aby dokázali medzi sebou interagovať,“ dodáva vedec.
Čaká ich dlhá cesta
Výskum by mohol byť ďalej významný aj v lepšom pochopení mozgu. Aj napriek tomu, že náš mozog kontroluje celé naše bytie a je zodpovedný za našu inteligenciu, stále nechápeme na akom princípe vlastne funguje.
V súčasnosti ho neurovedci považujú za akýsi biologický počítač a predpokladajú, že funguje na obdobnom princípe ako tie mechanické, no okolo samotného orgánu existuje stále mnoho otázok.
Spomínaný projekt, ktorý tím vedcov pomenoval „DishBrain“, má pred sebou ešte dlhú cestu a výskumníci ho plánujú využiť na množstvo ďalších experimentov. Najbližšie majú na pláne tento umelý mozog „opiť“ či vystaviť efektom rôznych drog a liečiv, aby zistili, či na hru reaguje iným spôsobom, ako je to v prípade bežného ľudského mozgu.
Čítaj viac z kategórie: Zaujímavosti
Zdroje: France24, ScienceAlert, Futurism